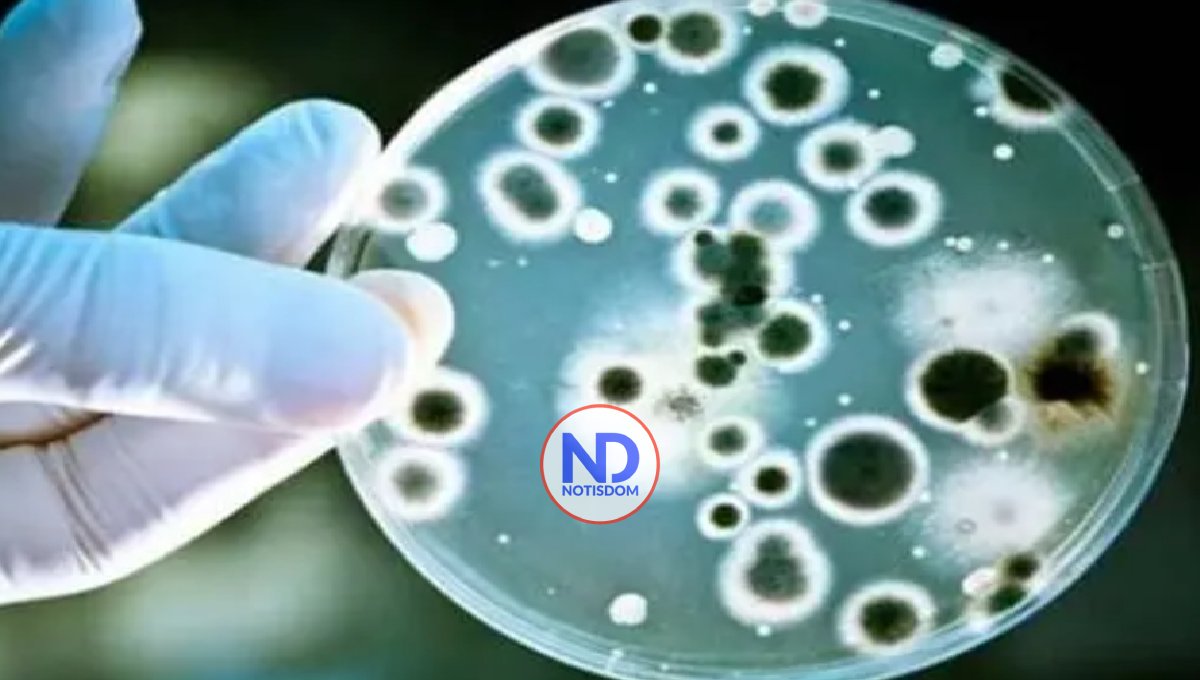
OMS elabora lista de hongos más peligrosos para la salud humana

OMS elabora lista de hongos más peligrosos para la salud humana
GINEBRA.- La Organización Mundial de la Salud (OMS) presentó hoy por primera vez una lista con los 19 hongos infecciosos más peligrosos para la salud pública y alertó sobre que su presencia en pacientes es cada vez más común, mientras que los tratamientos contra ellos todavía no están lo suficientemente desarrollados.
Los hongos están divididos en tres categorías según su nivel de riesgo para los seres humanos, y cuatro de ellos son considerados de especial peligrosidad- el criptococcus neoformans, el aspergillus fumigatus, y dos hongos del género cándida (el auris y el albicans).
El primero de ellos puede causar neumonías agudas y meningitis, el aspergillus puede ser particularmente peligroso en pacientes inmunodeprimidos, y los hongos del género cándida pueden causar infecciones vaginales, orales, intestinales o de otro tipo, conocidas comúnmente como candidiasis.
La OMS advierte con la publicación de esta lista que la mayoría de estos patógenos no tienen todavía sistemas de diagnóstico rápido, o éstos no están accesibles en todos los países, mientras que sólo hay accesibles en el mercado cuatro clases de medicinas fungicidas, con muy pocas más en procesos de investigación.
En sus formas más invasivas, estos hongos pueden ser especialmente graves para grupos de riesgo tales como enfermos de cáncer, seropositivos, personas que han recibido un órgano trasplantado, afectados de enfermedades respiratorias crónicas o infectados de tuberculosis.
Según los expertos de la organización con sede en Ginebra, las infecciones de estos hongos, de las que todavía no se tienen estadísticas completas, están aumentando debido al cambio climático y el aumento de los viajes internacionales, con especial ascenso de las infecciones en hospitales.
También se advierte un aumento de la resistencia de estos hongos a los tratamientos, algo que se ha advertido en casos de candidiasis oral o vaginal, lo que aumenta el riesgo de desarrollo de especies más peligrosas.
“Las infecciones por estos hongos reciben poca atención y recursos”, lo que contribuye al por ahora escaso conocimiento sobre la distribución y extensión en muchas áreas geográficas, advierte la OMS.
El uso inadecuado de fungicidas, por ejemplo en la agricultura, está aumentando el problema al desarrollar especies más resistentes a tratamientos, por ejemplo en el caso del aspergillus fumigatus, subraya el organismo de Naciones Unidas.
